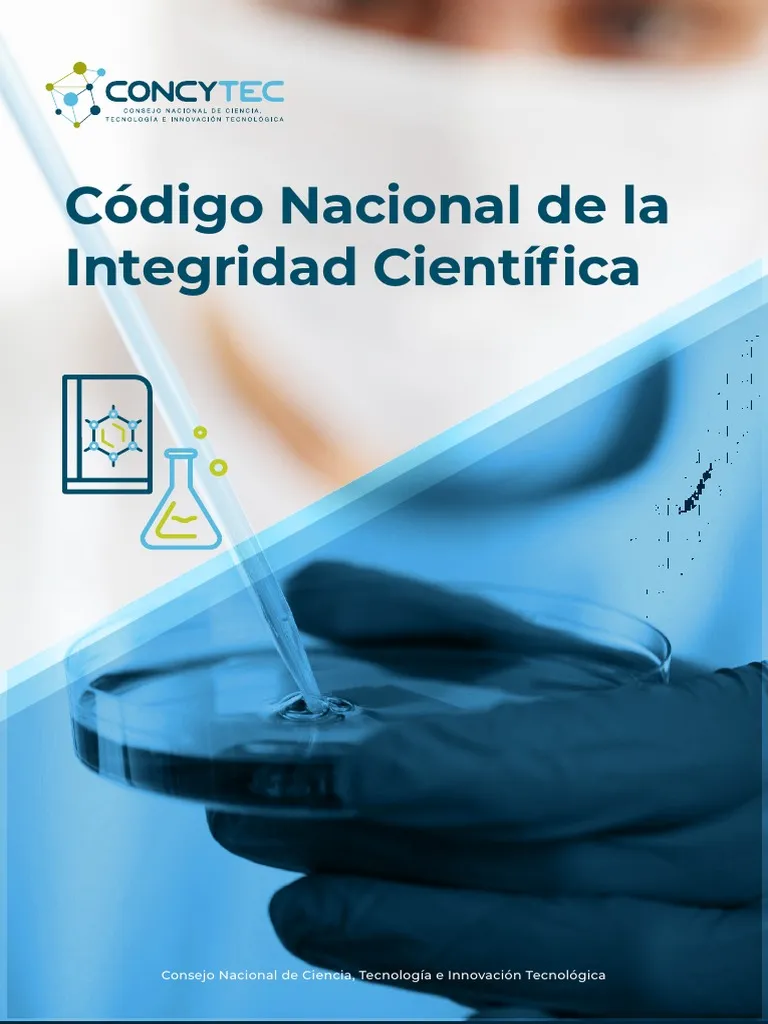

Oficina de Conducta Responsable en Investigación (OCRI)
En el año 2015 se crea la Oficina de Conducta Responsable en Investigación (OCRI), la cual se encuentra bajo la Dirección de Asuntos Regulatorios de la investigación (DUARI).
La Conducta Responsable en Investigación (CRI) es aquella conducta que refleja el compromiso e integridad de los investigadores al proponer, desarrollar, evaluar y publicar resultados de investigación, adhiriéndose a los principios generales y estándares de buenas prácticas en investigación. (Code of Conduct for responsible Research-WHO. OMS 2017) .
Nosotros
La OCRI es una oficina que tiene el propósito de desarrollar actividades dirigidas a la promoción de la integridad científica, y la prevención y manejo de alegatos de mala conducta científica (MCC).
Mala Conducta Científica
A cualquier acción que involucre la fabricación, falsificación o plagio, en el planteamiento, el desarrollo, el reporte de datos y/o la publicación de una investigación científica. Otras acciones u omisiones que transgredan los valores, principios y buenas prácticas que definen la integridad de la investigación científica y de las relaciones entre los investigadores, como las formuladas en el Código Nacional de Integridad Científica (Resolución de Presidencia N° 028-2024-CONCYTEC-P) también serán consideradas así.
Fabricación: es el reporte o publicación de datos ficticios o creados por el investigador.
Falsificación: es la manipulación de materiales, equipos o procesos de investigación, o la modificación u omisión de datos o resultados, de tal manera que los récords o resultados de la investigación ya no reflejan datos reales.
Plagio: apropiación de las ideas, procesos, resultados o palabras de otra persona, sin darle el crédito correspondiente.
Otras acciones incluyen la destrucción del experimento y cualquier otro acto de mala conducta científica que se derivan de la inobservancia y de la evasión que atentan con los principios morales esperados por la comunidad científica (Resolución de Presidencia N° 028-2024-CONCYTEC-P).
Cómo denunciar
Cualquier indicio, sospecha o evidencia que sugiera una MCC, deberá ser denunciada a la OCRI. Para formalizar esta denuncia, deberá ser presentada a través del correo electrónico, formulario de denuncias, por escrito en un sobre cerrado a la OCRI o solicitando directamente una reunión con el oficial de integridad científica en coordinación con el administrador de la OCRI, identificando claramente al denunciante y su información de contacto, al denunciado, y describiendo el caso.
Toda la información recibida a través de las consultas y/o denuncias, será mantenida en total confidencialidad.
Cualquier consulta adicional, sobre cómo presentar la denuncia o cualquier otra pregunta, podrá ser dirigida al Administrador de la OCRI (duari.ocri@oficinas-upch.pe).
Comité de Integridad Científica
Dr. Leandro Huayanay
Oficial de Integridad Científica
Mag. Carla Gallo
Miembro del CIC
Dr. Humberto Del Castillo
Miembro del CIC
Entrenamiento
El entrenamiento en Conducta Responsable en Investigación (CRI) es indispensable para garantizar que la investigación desarrollada en la Universidad Peruana Cayetano Heredia se adhiera a los principios institucionales de promoción de la integridad científica, la honestidad y el cumplimiento de las normas profesionales.
En ese marco, Cayetano Heredia pone a disposición de sus alumnos, docentes e investigadores diversos recursos para el entrenamiento en CRI, ética en investigación y otros aspectos vinculados a la conducta responsable en investigación, a través del CITI Program.
Desde el año 2022, la OCRI se ha encargado de la organización y el desarrollo de jornadas con la colaboración de expertos nacionales e internacionales, orientados a la actualización, capacitación y fortalecimiento de competencias en ética y conducta responsable en investigación, dirigidas a la comunidad herediana y a diferentes profesionales del sector salud e investigación.
Entre los principales eventos organizados se encuentran:
- Jornada “Ética y Conducta Responsable en Docencia e Investigación” (2022)
- I Jornada Internacional Científica sobre Conducta Responsable en Investigación (2023)
- II Jornada Internacional sobre Conducta Responsable en Investigación (2023)
- III Jornada Internacional Científica sobre Conducta Responsable en Investigación (2024)
- IV Jornada de Ética e Integridad Científica en Investigación (2024)
- V Jornada Internacional de Ética y Conducta Responsable en Investigación 2025
- VI Jornada Internacional sobre Conducta Responsable en Investigación (2025)
- VII Jornada Internacional de Ética y Conducta Responsable en Investigación (2026)



- Presentación del Reglamento de Integridad Científica de Cayetano Heredia:
Cayetano Heredia establece los siguientes requerimientos de entrenamiento en ética y CRI:
Estudiantes de Pregrado y Posgrado:
Contar con un certificado de entrenamiento en Ética y Conducta Responsable en Investigación menor de 3 años de antigüedad al momento de registrar su proyecto de investigación en el SIDISI (proyecto independiente o proyecto para optar el grado correspondiente).
Docentes/Investigadores contratados y nombrados:
Contar con un certificado de entrenamiento en Ética y Conducta Responsable en Investigación menor de 3 años de antigüedad al momento de registrar, en el SIDISI, su proyecto de investigación o al momento de ser listado como asesor en el registro de un proyecto de investigación en el SIDISI.
Se ofrecen los siguientes cursos virtuales en el CITI-Program:
· Ética en investigación que involucra humanos & CRI (Básico): este curso está dirigido para todos los investigadores de un proyecto que involucre seres humanos (Proyectos F1).
· Ética en investigación para el uso de animales & CRI (Básico): este curso está dirigido para todos los investigadores de un proyecto que involucre animales (Proyectos F2).
· Conducta Responsable en Investigación (Básico): este curso está dirigido para todos los investigadores de proyectos que no involucren humanos ni animales (Proyectos F3).
Además, los participantes de las Jornadas de Ética y Conducta Responsable en Investigación organizadas por la Universidad Peruana Cayetano Heredia pueden obtener una constancia con una vigencia de 3 años, la cual puede reemplazar al certificado del CITI-Program.
Módulo de Conducta Responsable en Investigación en el Programa de Iniciativa de Capacitación Institucional Colaborativa (CITI, por sus siglas en inglés).
Link: https://about.citiprogram.org/en/homepage/
Recursos adicionales
Contacto

Dr. Leandro Huayanay
Oficial de Integridad Científica
duari.ocri@oficinas-upch.pe
Lic. Silvia Román
Coordinadora de la OCRI
duari.ocri@oficinas-upch.pe